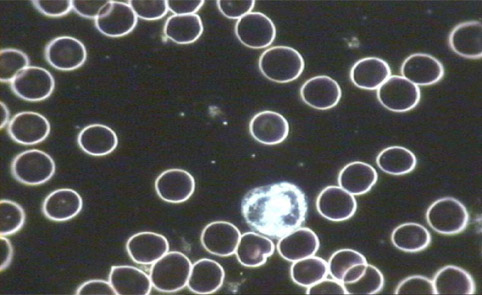
Dunkelfeldblut

Labordiagnostik mit Dunkelfeldmikrokopie
Prof. Dr. Günther Enderlein (1872-1968) war tätig in Berlin und Hamburg, wo er ein eigenes Institut leitete. Seine Beobachtungen veranlaßten ihn dazu, die Lehre von der Wandlungsfähigkeit der Mikroben wieder aufzugreifen und neu zu begründen.
Er fand heraus, daß Viren, Bakterien, Pilze, kurz Mikroorganismen, einen Formenwandel durchlaufen. Aus kleinsten Eiweißverbindungen kann somit eine Auf- und Abwärtsentwicklung von viralen- bakteriellen- bis hin zu Pilzwuchsformen stattfinden.
Enderleins Entdeckungen stehen somit im Gegensatz zur Lehrbiologie und Schulmedizin seiner und unserer Zeit. Auch wenn er im Ausland große Beachtung fand und mehrere Auszeichnungen angesehener Universitäten erhielt, wurde er bei uns nicht gewürdigt.
Der menschliche Organismus lebt, wie wir wissen, in ständiger Symbiose mit den verschiedensten Kleinstlebewesen. (wie z.B. mit den Bakterien im Darm)
So ist auch das Blut von mehreren Mikroorganismen besiedelt. Nach Enderlein lassen sich diese verschiedenen Entwicklungskreisläufen zuordnen. Für unseren Organismus erreichen hierbei zwei Entwicklungslinien eine zentrale Bedeutung; dies sind die vielfältigen Formvariationen aus der Entwicklung von Mucor-racemosus und Aspergillus-niger.
Die niederen Formen dieser beiden Entwicklungen sind für uns als Blutsymbionten unschädlich. Sie sind sogar unersetzlicher Teil des Gesamtorganismus. So beeinflussen sie ganz wesentlich den Zustand des Blutes, seine Gerinnungsfähigkeit, die Beweglichkeit und Lebensdauer von Blutkörperchen, die Fließeigenschaften, den Knochenbau und vieles mehr. Darüber hinaus sind die niederen Formen in der Lage, die schädlichen Entwicklungsformen abzubauen und hierdurch ihr Auftreten in Grenzen zu halten. Erst wenn sich ihr Lebensumfeld, das Milieu verändert, entstehen hieraus pathogene- d.h. krankmachende- Formen.
Die falsche Lebensweise und Ernährung beeinflussen massiv diese Selbstregulation und fördern so die Aufwärtsentwicklung der Mikroben mit der Folge verschiedener Krankheiten.
Einer der beiden im Blut und Gewebe lebenden Symbionten (Mucor racemosus) bewirkt in seiner Höherentwicklung unter anderem eine zunehmende Eindickung und Verlangsamung des Blutes. Es kommt zu Durchblutungsstörungen und deren Folgeerscheinungen, venösen Stauungen, Thrombosen, Krampfadern, Hämorrhoiden, Beingeschwüre, bestimmten Formen des Bluthochdrucks, des Glaukoms, Arteriosklerose u.v.m.
Die andere Entwicklungslinie (Aspergillus niger) – stellt in ihrer Bakterienphase die Unterformen des Tuberkulose-Bakteriums und hat u.a. Anteil an rheumatischen Erkrankungen, Knochenveränderungen und Geschwulstbildungen.
Da die Entwicklung der Mikroben stets nicht nur aufwärts, sondern auch abwärts erfolgen kann, war es nur noch ein konsequenter Schritt zur therapeutischen Nutzung dieser Erkenntnisse. Enderlein wie auch viele weitere Forscher haben diese Therapien entwickelt. Sie besteht im wesentlichen in der Anregung der Eigenregulation durch eine Milieutherapie und der Zufuhr von niedrigsten Entwicklungsstufen, welche dann in der Lage sind, die schädlichen Formen abzubauen. Die Krankheitserscheinungen werden hierdurch von ihrer elementaren Ebene aus behandelt.
Relativ gesundes Blut mit Erythrozyten, einem Leukozyt und einigen Thrombozyten